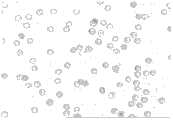

Summary of the invention
Technical matters to be solved by this invention is; Not enough to prior art; Providing a kind of utilization morphological feature parameter and neural network that erythrocytic source and character in the sample are carried out statistical method expresses; For the related personnel with reference to judging whether red cell morphology normal, the red blood cell morphology analytical equipment and the method thereof of assistant identification red blood cell source and character.
For solving the problems of the technologies described above, the technical scheme that the present invention adopted is: a kind of red blood cell morphology analytical equipment, and it comprises:
A. a micrometron, the low power objective head of this micrometron scans the sample in set zone, and mark is given in the target area of finding, and by the high power objective head of this micrometron marked region is scanned simultaneously;
B. a video camera or CCD element, this video camera or CCD element carry out the image information collection to marked region;
C. one in order to carry out the image digitizer of analyzing and processing to above-mentioned image; This image digitizer is cut apart the location with the image of gathering according to contained red blood cell earlier; Again the image after cutting apart is carried out digitized processing, promptly extract each erythrocytic size, shape, colourity and four types of morphological feature parameters of texture;
D. the sorter that is based upon on the neural net base, the size of each cell that is used for obtaining according to above-mentioned steps, shape, colourity and four types of morphological feature parameters of texture are isolated red blood cell from various types of cells;
E. the Feature Fusion device that is based upon on the fuzzy clustering basis; This Feature Fusion device is used for that the isolated erythrocytic size of above-mentioned steps, shape, colourity and four types of multidimensional morphological features of texture parameter are carried out the normalization dimension-reduction treatment and obtains size, shape, colourity and 4 eigenwerts of texture; Carry out statistical computation and statistical graph respectively according to all erythrocytic sizes, shape, colourity, textural characteristics in the sample again and express, for red blood cell classification and source in the analyzing samples provide true objective basis;
F. an output device is used for visual display detecting result;
G. a control module, this control module connects above-mentioned micrometron, video camera or CCD element, image digitizer and output device respectively, to control this micrometron, video camera or CCD element, image digitizer and output device action.
This output device gives expression to the characteristic parameter data combination of the peculiar representative red blood cell of all kinds red blood cell central area size, shape, colourity and texture; Erythrocytic Analysis and Identification method in the sample is that the change according to red blood cell central area characteristic comes erythrocytic source or erythrocytic type in the judgement sample.
Red blood cell morphology analytical approach in the sample; The all kinds red blood cell that is the different meanings of representative of the clinical affirmation of reference has different morphological feature supplemental characteristics; Carry out the discriminator counting in view of the above, the ratio that the similar morphological feature supplemental characteristic that a certain morphological feature supplemental characteristic combination accounts for total red blood cell according to all types of red blood cells in the sample again makes up is expressed with figure or data mode after statistical procedures.
As analytical approach and detection means wherein; The statistical method analysis-by-synthesis is used in all types of erythrocytic two or more red blood cell morphology characteristic parameters combinations in the sample; Obtain all types of red blood cell multi parameter analysis results in the sample; Change the judgement red blood cell morphology according to it and change, give expression to red blood cell morphology change type in the sample intuitively through figure and data.
Utilize this device to carry out red blood cell and analyze expressed identical result; In different samples, has the different clinical meaning; When occurring the small size hypochromic erythrocyte in the sample; The result that this device analysis goes out is that single erythrocyte volume is little, colourity is low, and total red blood cell morphological feature parameter is a horizontal ordinate with the parameter combinations of representing size, and the characteristic parameter data of expression colourity are that the morphological analysis avatars of ordinate is the RDW increase skew of turning left; The red cell distribution zone is to moving down; Be expressed as the red cell morphology distribution plan that disperses to sinking left, one type of anaemia of prompting appears in this type of figure in blood sample, derives from kidney property red blood cell if in urine specimen, occur and account for certain proportion then mean; During like the big volume high luminance relay element of appearance in sample red blood cell; The result that this device analysis goes out is that single erythrocyte volume is big, colourity is high; Total red blood cell morphological feature parameter is a horizontal ordinate with the parameter combinations of representing size; The characteristic parameter data of expression colourity are that the morphological analysis avatars of ordinate is the RDW increase skew of turning right, and the red cell distribution zone is upwards moved, and is expressed as the red cell morphology distribution plan that disperses to rising to the right; The another kind of type anaemia of prompting appears in this type of figure in blood sample, derive from non-kidney property red blood cell if in urine specimen, occur and account for certain proportion then mean.
The invention also discloses a kind of red blood cell morphology analytical approach, it comprises the following steps:
Step 1: scan with the low power objective head of micrometron sample, mark is given in the target area of finding, and by the high power objective head of this micrometron marked region sample is scanned simultaneously to set zone;
Step 2: marked region sample is carried out the image information collection with video camera or CCD element;
Step 3: the image of gathering is cut apart the location according to contained cell earlier with image digitizer; Again the image after cutting apart is carried out digitized processing; Promptly extract the morphological feature parameter of each cell, describe each cell with size, shape, colourity and texture four category features;
Step 4: the size of each cell that above-mentioned steps is obtained, shape, colourity and four types of morphological feature parameters inputs of texture are based upon the sorter on the neural net base, from various types of cells, isolate red blood cell size, shape, colourity and four types of morphological feature parameters of texture by this sorter;
Step 5: erythrocytic size, shape, colourity and four types of morphological feature parameter inputs of texture thatstep 4 is separated are based upon the Feature Fusion device on the fuzzy clustering basis; By this Feature Fusion device each type multidimensional morphological feature parameter is carried out normalization and handle, obtain the one-dimensional characteristic vector;
Step 6: all erythrocytic each type normalization characteristic quantities in each sample are shown through output device, promptly draw the statistics chart of each type normalization characteristic parameter.
Above-mentioned red blood cell morphology analytical approach also comprises step 7: the ratio that accounts for the total red blood cell number according to all types of red blood cells in the sample is expressed with figure or data mode through statistical procedures, and red blood cell in the sample is carried out Analysis and Identification;
Above-mentioned red blood cell morphology analytical approach; Also comprise step 8: vectorial through normalized morphological feature to each type; Through providing a characteristic quantity threshold values; Calculating is higher than or the red blood cell that is lower than threshold values accounts for the ratio of the similar morphological feature supplemental characteristic combination of sample total red blood cell, after statistical procedures, expresses with figure or data mode, so that the objective basis of red blood cell in the sample being carried out Analysis and Identification to be provided.
This sorter that is based upon on the neural net base comprises a feedback procedure; This feedback procedure is that suspicious object and identification error target that classification is come out are carried out refinement, classification, complementary features parameter; And set up corresponding mathematical model; Neural network is trained, neural network learn automatically and remember those refinements, classification, additional characteristic parameter gets into model database, the sorter that returns again based on neural network carries out cytological classification.
The normalized size characteristic vector that draws in the step 6 gives expression to the peculiar characteristic parameter data combination of representing size of all kinds red blood cell; Red blood cell Analysis and Identification method in the sample; Can compare according to red blood cell size distribution and normal erythrocytic size distribution, come erythrocytic source or erythrocytic type in the judgement sample according to direction that departs from and degree.
The normalized shape facility vector that draws in the step 6 gives expression to the characteristic parameter data combination of the peculiar representative shape of all kinds red blood cell; Erythrocytic Analysis and Identification method in the sample can be come erythrocytic source or erythrocytic type in the judgement sample according to the variation of red blood cell parameters for shape characteristic.
The normalized such chroma feature vectors that draws in the step 6 gives expression to the characteristic parameter data combination of the peculiar representative colourity of all kinds red blood cell; Erythrocytic Analysis and Identification method in the sample can be compared with normal red blood cell colourity according to red blood cell colourity and come erythrocytic source or erythrocytic type in the judgement sample according to the direction and the degree that depart from.
The normalized texture feature vector that draws in the step 6 gives expression to the characteristic parameter data combination of the peculiar representative texture of all kinds red blood cell; Erythrocytic Analysis and Identification method in the sample can be come erythrocytic source or erythrocytic type in the judgement sample according to the variation of red blood cell textural characteristics parameter.
To erythrocytic Analysis and Identification in the sample, adopt wherein any one separately and analyze, or comprehensively adopt wherein many and analyze.
Compared with prior art; The beneficial effect that the present invention had is: the present invention places microscopically to amplify that each cytomorphology image of sample is taked by CCD in the back in sample (blood, urine) and through obtaining the morphological feature parameter of each cell after the Digital Image Processing; The sorter that the parameter input is based upon on the neural net base is isolated each red blood cell; Through the Feature Fusion device that is based upon on the fuzzy clustering basis all kinds of red cell morphology characteristic parameter data are carried out the normalization processing, each type normalized parameter that obtains is carried out statistical study respectively again; Or carry out the comprehensive statistics analysis according to several types of parameters; Mode with figure or numerical table is expressed, and judges with this whether erythrocytic form normal, through to all kinds of abnormal morphologies erythrocytic detection can identify red blood cell source and character.
The present invention is on original urine cell recognition basis; Consider that possibly there is error in identification to software to respective intended; We have introduced morphology parameter and statistical analysis technique thereof; Adopt this method, instrument can be analyzed the red blood cell source in the blood urine sample automatically according to the statistical study of all target components in the sample.This method has reduced the error effect that the respective intended identification error brings owing to adopt the interior all targets of sample to add up judgement.Be that statistical method is in the application innovation analytically of urine RBC morphology parameter.
Description of drawings
Fig. 1 is a red blood cell morphology analytical equipment structural representation of the present invention.
Fig. 2 is the operating process synoptic diagram of red blood cell morphology analytical approach of the present invention.
Fig. 3 is the Feature Fusion algorithm principle figure of PCA weighting.
The dispersion of distribution, the peak value synoptic diagram of Fig. 4 for mentioning among the present invention.
Fig. 5 is the normal morphology erythrogram that digital CCD takes.
Fig. 6 .1 is a normal morphology red blood cell size characteristic parametric statistics curve map, its dispersion of distribution a<L, its peak value be b in normal range, D1<b<D2.
Fig. 6 .2-Fig. 6 .9 representes for the another kind of Fig. 6 .1.
Fig. 7 is normal morphology red blood cell parameters for shape characteristic statistic curve figure, and it distributes and concentrates, and the dispersion of distribution is little, frequency value C>H (60%) that peak value is corresponding.
Fig. 8 is a normal morphology red blood cell chromaticity parametric statistics curve map, is single narrow peak, and it distributes and concentrates, frequency value C>H (60%) that peak value is corresponding.
Fig. 9 is a normal morphology red blood cell textural characteristics parametric statistics curve map, the corresponding X axis values of its peak value b in normal range, W1<b<W2.
Figure 10 is that scatter diagram is analyzed in erythrocytic size of normal morphology and chromaticity parametric synthesis, and the normal morphology red blood cell is concentrated and is distributed between 75<X<125 and 20<Y<40.
Figure 11 is the gemma shape erythrogram of digital CCD picked-up, and the gemma red blood cell has the outstanding or cell of vesicle to be mycotic spore appearance at the red blood cell adventitia and changes.Volume is uneven, the distortion shape of gemma is arranged, colourity is shallow usually.The expression of its characteristic parameter statistical graph is shown in Figure 12-15.Normal shape red blood cell is represented to compare with dashed lines among the figure.
Figure 12 is a gemma shape red blood cell size characteristic parametric statistics curve map, compares with normal shape red blood cell, because size is uneven and because of gemma trend bigger than normal is arranged, a is big for its size characteristic parametric statistics figure dispersion of distribution, distributes not concentrate; Andform 1 with upward peak, the corresponding reduction of peak value place frequency.Its dispersion of distribution a>L sees that from figure width is bigger than normal shape RDW a, and expression red blood cell size distribution is uneven.B>D2, part red blood cell size is bigger than normal.
Figure 13 is gemma shape red blood cell parameters for shape characteristic statistic curve figure, and C is less than the normal morphology red blood cell for the corresponding frequency value of its peak value, C<H (60%).
Figure 14 is a gemma shape red blood cell chromaticity parametric statistics curve map; Its gemma shape red blood cell colourity average significantly reduces, and the corresponding frequency value of its peak value C all is significantly less than normal morphology red blood cell, C<H; And the gemma shape red blood cell colourity dispersion of distribution changes little, and it is narrower unimodal that cell distribution evenly is.。
Figure 15 is a gemma shape red blood cell textural characteristics parametric statistics curve map, and the normal red blood cell of gemma red blood cell texture is complicated, its textural characteristics parametric statistics figure, and b is bigger for the corresponding X axis values of texture peak value, b>W2.
Figure 16 is that scatter diagram is analyzed in erythrocytic size of gemma form and chromaticity parametric synthesis, and its red blood cell colourity is obviously on the low side, and the expansion of red blood cell magnitude range, mainly is distributed between 80<X<160.
Figure 17 is the big or small uneven erythrogram of digital CCD picked-up.Shape red blood cell not of uniform size refers to that diameter differs the situation more than a times between the red blood cell, is common in various hyperplastic anemias and megaloblastic anemia, and volume is not of uniform size, and colourity is shallow, and shape is normal.The expression of its characteristic parameter statistical graph is shown in Figure 18-22.Normal shape red blood cell is represented to compare with dashed lines among the figure.
Figure 18 is big or small uneven shape red blood cell size characteristic parametric statistics curve map, and its dispersion of distribution a>L sees that from figure width is bigger than normal shape RDW a, and expression red blood cell size distribution is uneven.B>D2, part red blood cell size is bigger than normal.
Figure 19 is big or small uneven shape red blood cell parameters for shape characteristic statistic curve figure, and C is less than the normal morphology red blood cell for the corresponding frequency value of its peak value, C<H (60%).
Figure 20 is big or small uneven shape red blood cell chromaticity parametric statistics curve map.The uneven red blood cell colourity average of size is higher, and the corresponding frequency value of its peak value C all is significantly less than the normal morphology red blood cell, C<H (60%).Its dispersion of distribution obviously increases than general orientation toward chromatic value.
Figure 21 is big or small uneven shape red blood cell textural characteristics parametric statistics curve map.
Figure 22 is that scatter diagram is analyzed in erythrocytic size of big or small uneven shape and chromaticity parametric synthesis, shows among the figure that erythrocytic colourity and size distribution scope are big, 5<X<30 and 40<Y<150.
Figure 23 is small size hypochromic erythrocyte (anaemia or kidney property) characteristic parameter analysis-by-synthesis scatter diagram.
Figure 24 accounts for the ration statistics figure of total red blood cell number for various cells in the sample.
Figure 25 is the same this colourity characteristic parameter statistical graph.
Figure 26 is that of Figure 24 changes expression-form.
The statistical graph that Figure 27 expresses for the mode of arranging with many figure.
Embodiment
Fig. 1 is the synoptic diagram of red blood cell morphology analytical equipment of the present invention.As shown in the figure, red blood cell morphology analytical equipment of the present invention comprises:
A. amicrometron 1, the low power objective head of thismicrometron 1 scans the sample in set zone earlier, and mark is given in the target area of finding, and by the high power objective head of thismicrometron 1 marked region sample is scanned simultaneously;
B. a video camera or CCD element 2,2 pairs of this video camera or CCD elements marked region sample carry out the image information collection;
C. an image digitizer 3 in order to the numeral that produces above-mentioned image; This image digitizer 3 is cut apart the location with the image of gathering according to contained cell earlier; Again the image after cutting apart is carried out digitized processing, promptly extract size, shape, colourity and four types of morphological feature parameters of texture of each cell;
D. the sorter that is based upon on the neural net base, the size of each cell that is used for obtaining according to above-mentioned steps, shape, colourity and four types of morphological feature parameters of texture are isolated red blood cell from various types of cells;
E. theFeature Fusion device 4 that is based upon on the fuzzy clustering basis, each type multidimensional morphological feature parameter that this Feature Fusion device is used for above-mentioned steps is obtained carry out normalization to be handled, so that red blood cell statistical classification foundation to be provided;
F. an output device 6, this output device 6 can comprise watch-dog and printer, is used for visual display detecting result;
G. a control module 5; This control module 5 connects above-mentionedmicrometron 1, video camera or CCD element 2, image digitizer 3 and output device 6 respectively, to control thismicrometron 1, video camera or CCD element 2, image digitizer 3 and output device 6 actions.
In the present embodiment, the neural network that adopts in thissorter 7 is based on the BP three-layer neural network of RDROP algorithm, and this three-layer neural network comprises an input layer, an output layer and a middle layer under covering.And the data of this neural network are extendible, have from Memorability.This neural network is used for expert system training and sample object identification.Certainly, this sorter also can adopt the neural network of other types.
About neural network, there have been a lot of data that it has been carried out detailed introduction, thereby do not done too much narration at this.
Neural network of the present invention has a plurality of input nodes, and each input node is expressed a certain morphological feature parameter of cell to be measured.Those morphological feature Parameter Extraction methods and morphological feature parametric classification state description are following:
1. feature extracting method
At first through the great amount of samples picture; Visible component in the samples pictures is classified according to the red blood cell morphology characteristic by expert's manual work; Set up the classification semantic model according to this, set up the classification mathematical model on this basis, thereby define erythrocytic various morphological feature; One has four big category features, comprises size characteristic, shape facility, chromaticity, textural characteristics.
2. tagsort
The present invention has extracted nearly 100 multidimensional target signatures, below is merely characteristic features and describes:
2.1 size characteristic comprises area, girth, equivalent diameter, major axis, minor axis, mean radius etc.;
2.2 shape facility: shape facility is used to describe the form of target, mainly comprise round rate, eccentricity, regional barycenter, curvature, regional string distributional pattern descriptor correlated characteristic, edge fitting polygon form descriptor, Fourier coefficient form depicted features vector, based on the form of convex closure correlated characteristic is described, based on the feature description of boundary rectangle, describe and based on the shape facility of regional skeletal extraction totally 26 characteristics based on the shape facility of displacement characteristic not.Wherein regional string distributional pattern descriptor, describe correlated characteristic, describe and be the new method of the description form that proposes among the present invention based on the feature description of boundary rectangle, based on the shape facility of displacement characteristic not based on several category features such as shape facility of regional skeletal extraction based on the form of convex closure;
2.3 chromaticity: comprise based on HSV target area color histogram, based on the regional aim Dominant Color Features of probability window extract, the color distance;
2.4 textural characteristics is based on the multi-dimension texture characteristic of wavelet transformed domain: it comprises that the textural characteristics of multi-scale wavelet energy proportion, multi-scale wavelet standard deviation, comprehensive co-occurrence matrix, the Zernike moment characteristics that merges the texture spectrum describe.
Specifically, as shown in Figure 2, the operation steps of red blood cell morphology analytical approach of the present invention is:
Step 1: earlier the sample in set zone is scanned with the low power objective head ofmicrometron 1, mark is given in the target area of finding, and by the high power objective head of thismicrometron 1 marked region is scanned simultaneously;
Step 2: carry out the image information collection with 2 pairs of video camera or CCD elements marked region, Fig. 5, Figure 11, Figure 17 are the erythrogram that collects; The normal morphology red blood cell, the cell size is more consistent, and cell space is normal or bigger than normal, and haemoglobin is abundant, and no gemma forms, and cell membrane is complete.All kinds of parametric statistics curve maps are essentially normal distribution, and distributed areas are more concentrated.
Step 3: the image with 3 pairs of collections of image digitizer is cut apart the location according to contained cell earlier; Again the image after cutting apart is carried out digitized processing; Promptly extract the morphological feature parameter of each cell, describe each cell with size, shape, colourity and texture four category features
Step 4: the size of each cell that step 3 is obtained, shape, colourity and four types of morphological feature parameters inputs of texture are based upon the sorter on the neural net base, from various types of cells, isolate red blood cell by this sorter; Following table is different types of some erythrocytic Partial Feature parameters table for example:
This sorter that is based upon on the neural net base comprises a feedback procedure; This feedback procedure is that suspicious object and identification error target that classification is come out are carried out refinement, classification, complementary features parameter; And set up corresponding mathematical model; Neural network is trained, neural network learn automatically and remember those refinements, classification, additional characteristic parameter gets into model database, the sorter that returns again based on neural network carries out cytological classification.
Step 5: the isolated erythrocytic morphological feature parameter input ofstep 4 is based upon the Feature Fusion device on the fuzzy clustering basis, carries out normalization by this Feature Fusion device and handle, obtain the one-dimensional characteristic vector;
Each category feature parameter that the concrete operations reality of this Feature Fusion device will initially obtain exactly draws a normalized eigenwert through the Feature Fusion algorithm computation based on the PCA weighting.
Specify the Feature Fusion algorithm of introducing this PCA weighting below:
1. Fig. 3 is the Feature Fusion algorithm principle figure of this PCA weighting.At first, input training sample n dimensional feature vector, this n dimensional feature vector can be size, shape, texture, such chroma feature vectors.Then, carry out feature extraction through the PCA algorithm, feature extraction is divided into the K-L characteristic and presses peacekeeping principal component feature selecting.Select size characteristic, shape facility, textural characteristics, chromaticity respectively in the principal component characteristic vector space that after feature extraction, obtains.Then these proper subspaces are carried out proper vector normalization, unite the weight of each dimensional vector again and carry out weighting fusion, each proper subspace obtains a corresponding characteristic quantity after through weighting fusion, and it being melted is the one-dimensional characteristic vector again.
2. particularly, the feature selecting algorithm principle based on PCA is:
If input primitive character space F={f1, f2..., fn, it is obtained the orthogonal characteristic vector space { x that the character pair value is arranged from big to small through the K-L orthogonal transformation1, x2..., xn, each proper vector is character pair value (λ respectively1, λ2..., λn).Obtain pressing the characteristic vector space after the dimension through the contribution rate that adds up, the contribution rate that adds up is suc as formula (1):
If emThe minimum m that>e (e is the contribution rate threshold value, 0<e≤1) then selects to satisfy condition (m≤N).Get { x1, x2..., xnPreceding m presses proper vector after the dimension as characteristic vector space V={x1, x2..., xm.
The target of PCA is exactly the m dimension principal component proper vector that extracts primitive character space F through this orthogonal vector matrix V.Its principle is with original feature vector { f1, f2..., fnAlong xjDuring direction projection, PCA will make the f that obtains1Energy is maximum, at this moment f1Be called first principal component; With x1Under the condition of quadrature, the primitive character space is at x2On projection, make f2Energy is maximum, at this moment is called second principal component, can obtain principal component feature space Y={f by that analogy1, f2..., fm.
3. characteristic normalization
Select colourity, texture, shape, size characteristic subspace Y respectively at principal component feature space Yc, Yt, Ys, Ye, the subspace expression formula is suc as formula (2):
Respectively to each the dimensional feature vector normalization in colourity, texture, shape, the size characteristic subspace, the normalization formula is suc as formula (3):
F whereinPiBe i eigenwert in the p dimensional feature vector, fPmaxAnd fPminBe respectively minimum and maximum eigenwert in the p dimensional feature vector.Through type (3) obtains the proper subspace Y after the normalizationCn, YTn, YSn, YEn
4. based on the Feature Fusion of weight function
Because normalized proper subspace extracts in the principal component feature space, the contribution ability that can know each dimensional feature vector has the branch of size, so shared weight is also different.But the contribution ability that the average of calculated characteristics vector and standard variance are described proper vector, computing formula are suc as formula (4):
μ in the formulapAnd σpAverage and the standard variance of representing the p dimensional vector respectively.
Capable of using | μp| and σpThe distinguishing ability of the cost function assessment characteristic below the definition, valuation functions are suc as formula (5):
Jp=|μp|/σp (5)
JpThe distinguishing ability that shows this characteristic more greatly is strong more, available JpRepresent the weight that each is vectorial.The weight vectors that then each vector is corresponding is (J1, J2..., Jd), d is the intrinsic dimensionality of a certain proper subspace.Can proper subspace be merged through matrixing and obtain the one-dimensional characteristic value.Matrixing is suc as formula (6):
(a1, a2..., am)TIn element aiRepresent i training sample corresponding with a certain proper subspace dimensionality reduction after eigenwert.This eigenwert all normalizes between 0~1, and sectional is represented all types of characteristics.
One-dimensional characteristic vector space (a of the normalization colourity after can obtaining merging through this method, texture, shape, size characteristicc, at, as, ae)T
Step 6: all erythrocytic each type normalization characteristic quantities in each sample are shown through output device, promptly draw the statistics chart of each type normalization characteristic parameter;
Step 6.1
Draw sample size, shape, colourity, texture four category feature parametric statistic charts respectively; Compare according to four category feature parametric statistic distribution plans of making and normal erythrocytic size distribution, come erythrocytic source or erythrocytic type in the judgement sample according to direction that departs from and degree.
Sample size, shape, colourity, texture four category feature parametric statistic data plots are expressed mode and are not limited, and can be histogram, distribution plan, scatter diagram, curve map, histogram, area-graph, pie chart, scatter diagram, circular chart, radar map, bubble diagram, cylindrical plot etc.
Normalized size characteristic vector after step 6.1.1 uses and merges is made red blood cell size distribution characteristic curve, like Fig. 6 .1-Fig. 6 .9, Figure 12 and shown in Figure 180.Horizontal ordinate is a sizes values, and ordinate is the frequency that corresponding sizes values occurs.
Erythrocytic size distribution situation in the main reflected sample of red blood cell size characteristic.Red blood cell size distribution characteristic curve moves to left to microcyte sexually revises, and curve moves to right to macrocyte sexually revises, and curve a plurality of peak values occur and shows that promptly red blood cell varies, and has inhomogeneity.If peak value is little, then cell volume is little; Peak value is big, and cell volume is big.Under the situation that a plurality of peak values occur, then expression has the uneven cell that mixes of obvious size, through multi-peak and reference value relatively can be drawn cell size distribution situation.The size of the dispersion of distribution of frequency shows the intensity of cell size.Compare according to sample red blood cell size distribution and normal erythrocytic size distribution and to come erythrocytic source or erythrocytic type in the judgement sample according to the direction and the degree that depart from.
Like Fig. 6 .1, be a statistical graph that comprises the size characteristic parameter of normocytic urine specimen, the mode with curve shows here.But characteristic parameter statistic curve figure can express by statistical graph in a variety of forms, shown in Fig. 6 .2-Fig. 6 .9, is normal morphology red blood cell size characteristic parametric statistics figure.
For more convenient explanation statistical graph, as shown in Figure 4, a representes the dispersion of distribution in the statistical graph.With regard to the size characteristic statistic curve, when the red blood cell size is close more, dispersion of distribution a is more little.The red blood cell size is heterogeneity more, and dispersion of distribution a is big more.Set dispersion of distribution threshold values L, in the time of dispersion of distribution a>L, can judge that this sample red blood cell is big or small uneven red blood cell, the uneven red blood cell of the doubtful size of system prompt sample.
B is the corresponding X axis values of statistical graph distribution peak value, when the b value changes, under the situation of statistical graph with curve representation, shows as moving to left or moving to right of curve.If the minimum threshold values D1 of peak value, maximum threshold values D2.When D1<b<D2, the red blood cell size is in normal range.As b<D1, curve moves to left, the doubtful microcyte of system prompt sample; As b>D2, curve moves to right, the doubtful macrocyte of system prompt sample.
Figure 12, Figure 18 are red blood cell size characteristic statistical graph illustration.Figure 12 explains gemma shape red blood cell size characteristic, has the outstanding or cell of vesicle to be mycotic spore appearance at gemma shape red blood cell adventitia and changes.Figure 18 explains big or small uneven red blood cell size characteristic.Red blood cell size distribution width a>L of 2 figure sees that from figure width is bigger than normal shape RDW a, and expression red blood cell size distribution is uneven.B>D2, part red blood cell size is bigger than normal.
Normalized shape facility vector after step 6.1.2 uses and merges is made red blood cell shape distribution curve, like Fig. 7, Figure 13 and shown in Figure 19.Horizontal ordinate is the shape facility value, the frequency that ordinate occurs for the character pair value.
Red blood cell shape distribution index mainly reflects lopsided red cell distribution situation.Use the characteristic parameter data combination (like circle rate, square frame rate, string distribution symmetry, protruding spore, inscribe etc.) of representing shape to analyze.Normocytic form is the double intended circle plate-like, and lopsided erythrocytic form is gemma appearance, shape of the mouth as one speaks shape etc.Variation according to the red blood cell parameters for shape characteristic comes erythrocytic source or erythrocytic type in the judgement sample.
Like Fig. 7, be a statistical graph that comprises the parameters for shape characteristic of normocytic urine specimen, this mode of sentencing curve shows.
With regard to the shape facility statistic curve, when red cell morphology more near the ideal standard red cell morphology, it is concentrated more to distribute, the dispersion of distribution is more little, the frequency value C bigger (0<C<100%) that peak value is corresponding.If the corresponding frequency threshold values of the peak value of shape facility statistic curve is H, this sentences H=60% is example, when C<H, and the doubtful more desirable red cell morphology that departs from of system prompt sample form.
Figure 13 and Figure 19 are red blood cell shape facility statistical graph illustration.Figure 13 is gemma shape red blood cell shape facility figure, has the outstanding or cell of vesicle to be mycotic spore appearance at gemma shape red blood cell adventitia and changes.Figure 19 explains big or small uneven red blood cell shape facility.The red blood cell distribution of shapes width of two figure is compared with normocyte and is changed not quite.And the corresponding frequency value of peak value C is all less than the normal morphology red blood cell, C<H.
Step 6.1.3 uses the normalized such chroma feature vectors after merging, and makes red blood cell colourity distribution characteristics curve, like Fig. 8, Figure 14 and shown in Figure 20.Horizontal ordinate is a chromatic value, and ordinate is the frequency that corresponding chromatic value occurs.
Red blood cell colourity distribution characteristics mainly reflects red blood cell hemochrome loss situation.On behalf of the characteristic parameter data combination (like tone, saturation degree etc.) of colourity, use analyze.Compare with normal red blood cell colourity according to red blood cell colourity and to come erythrocytic source or erythrocytic type in the judgement sample according to the direction and the degree that depart from.
Red blood cell is lost blood, and colourity can shoal behind the pigment, and this type of situation red blood cell colourity distribution characteristics frequency histogram curve can move to left, and peak value diminishes; Red blood cell is prone to dehydration and forms crenocyte in hypersthenuria liquid, colourity can deepen, and this type of situation colourity frequency histogram curve can move to right, and it is big that peak value becomes.This type situation does not belong to abnormal ranges, notes to differentiate judgement.
Like Fig. 8, be a statistical graph that contains the chromaticity parameter of normocytic urine specimen, this mode of sentencing curve shows.With regard to the chromaticity statistic curve, when red blood cell colourity more near normocyte colourity, it is concentrated more to distribute, the frequency value C bigger (0<C<100%) that peak value is corresponding.The corresponding frequency threshold values of the peak value of degree of filling in colors on a sketch characteristic statistics curve is H, and this sentences H=60% is example, and when C<H, red blood cell colourity is more in the system prompt sample departs from desirable red blood cell colourity.With regard to the chromaticity statistic curve, approaching more when the distribution of red blood cell colourity, the dispersion of distribution is more little.
B among Fig. 4 is the corresponding X axis values of statistical graph distribution peak value, when the b value changes, under the situation of statistical graph with curve representation, shows as moving to left or moving to right of curve, and just the depth of red blood cell colourity changes.Colourity is dark more, and the b value is big more; Colourity is shallow more, and the b value is more little.If the minimum threshold values S1 of the corresponding X axle of peak value, maximum threshold values S2.When S1<b<S2, red blood cell colourity is in normal range.As b<S1, curve moves to left, and expression cell colourity is on the low side, and as b>S2, curve moves to right, and expression cell colourity is higher.
Figure 14, Figure 20 are red blood cell chromaticity statistical graph illustration.Dotted line is represented normocyte colourity, is single narrow peak, explains that the colourity of cell is very even, does not have cytoplasmic losing.Erythrocytic colourity and content of hemoglobin have correlativity.Figure 14 explains gemma shape red blood cell chromaticity.Figure 20 explains big or small uneven red blood cell chromaticity.The red blood cell colourity average of two figure is compared all with the normal morphology red blood cell and is changed.Figure 14 gemma shape red blood cell colourity average significantly reduces, and the uneven red blood cell colourity average of Figure 20 size is higher.The corresponding frequency value of its peak value C all is significantly less than normal morphology red blood cell, C<H.Figure 14 gemma shape red blood cell colourity dispersion of distribution changes little, and it is narrower unimodal that cell distribution evenly is.The uneven RDW of Figure 21 size obviously increases than general orientation toward chromatic value.
Step 6.1.4 uses the normalized texture feature vector after merging, and makes red blood cell texture distribution characteristics curve, like Fig. 9, Figure 15 and shown in Figure 21.Horizontal ordinate is a texture value, and ordinate is the frequency that corresponding texture value occurs.
Red blood cell texture distribution characteristics is used and is represented red blood cell central area look ladder (like central authorities' pale district expansion, central pale district disappearance, the enhancing of central area colourity etc.) and represent the characteristic parameter data combination (as irregular grain, shrinkage etc. occurring) of texture to analyze.Compare with normal red blood cell texture according to the red blood cell texture and to come erythrocytic source or erythrocytic type in the judgement sample according to the direction and the degree that depart from.
Like Fig. 9, be a statistical graph that comprises the textural characteristics parameter of normocytic urine specimen, this mode of sentencing curve shows.With regard to the textural characteristics statistic curve, abundant more when the texture of red blood cell, its texture value is big more.As shown in Figure 4, a representes the dispersion of distribution in the statistical graph.The texture variations difference of cell is more little in sample, and the dispersion of distribution a of statistical graph is more little; The texture variations difference of cell is big more, and the dispersion of distribution a of statistical graph is big more.
B among Fig. 4 is the corresponding X axis values of statistical graph distribution peak value, when the b value changes, under the situation of statistical graph with curve representation, shows as moving to left or moving to right of curve, just the Strength Changes of red blood cell texture.Texture is strong more, and its energy is big more, and the b value is big more; Texture is shallow more, and the b value is more little.If the minimum threshold values W1 of the corresponding X axle of peak value, maximum threshold values W2.When W1<b<W2, the red blood cell texture is in normal range.As b<W1, the expression sample texture is thin and delicate, and curve moves to left; As b>W2, the expression sample texture is thicker, and curve moves to right.
Figure 15 explains gemma shape red blood cell textural characteristics.Figure 21 explains big or small uneven red blood cell textural characteristics.The red blood cell texture average of two figure is compared all with the normal morphology red blood cell and is changed.
Step 6.2 is used the statistical method analysis-by-synthesis with the normalization combination of eigenvectors of classification more than two kinds, obtains the multi parameter analysis chart;
Carrying out analysis-by-synthesis with red blood cell size and these two kinds of normalization combination of eigenvectors of colourity is example, like Figure 10, Figure 16, Figure 22 and shown in Figure 23.Horizontal ordinate is the red blood cell sizes values, and ordinate is corresponding red blood cell chromatic value, makes scatter diagram.
Figure 10 is among erythrocytic size of normal morphology and the colourity analysis-by-synthesis figure, and the normal morphology red blood cell is concentrated and is distributed between 75<X<125 and 20<Y<40.
Figure 16 is that red blood cell colourity is obviously on the low side among erythrocytic size of gemma form and the colourity analysis-by-synthesis figure, and the expansion of red blood cell magnitude range, mainly is distributed between 80<X<160.In the uneven shape red blood cell analysis-by-synthesis figure of Figure 22 size, erythrocytic colourity and size distribution scope are bigger, 5<X<30 and 40<Y<150.
Utilize this device to carry out the expressed identical result of red blood cell analytical approach; In different samples, has the different clinical meaning; When occurring the small size hypochromic erythrocyte in the sample; The result that this device analysis goes out is that single erythrocyte volume is little, colourity is low, and total red blood cell morphological feature parameter is a horizontal ordinate with the parameter combinations of representing size, and the characteristic parameter data of expression colourity are that the morphological analysis avatars of ordinate is the RDW increase skew of turning left; The red cell distribution zone is to moving down; Be expressed as the red cell morphology distribution plan that disperses to sinking left, the prompting anaemia appears in this type of figure in blood sample, derives from kidney property red blood cell if in urine specimen, occur and account for certain proportion then mean.
Shown in figure 23, the red cell distribution of P% in blood sample (50≤P≤100) is in X<75 and Y<20 intervals, the doubtful anaemia of system prompt sample; The red cell distribution of P% in urine specimen (50≤P≤100) is in X<75 and Y<20 intervals, the doubtful ephrosis of system prompt sample.
The ratio that step 7 accounts for the total red blood cell number according to all types of red blood cells in the sample is expressed with figure or data mode through statistical procedures, and red blood cell in the sample is carried out Analysis and Identification.
Shown in figure 24, through cell in the sample being discerned the back differential count, draw that various cells account for the wherein ratio of total red blood cell number in the sample.Under the expression situation through figure or data, the handled easily person is a foundation with these data, and the sample situation is made judgement.This mode of sentencing the statistics pie chart is expressed as example.
Step 7 is according to all types of erythrocytic normalized one dimension morphological feature vectors in the sample; Through providing a characteristic quantity threshold values; Calculating is higher than or the red blood cell that is lower than threshold values accounts for the ratio of the similar morphological feature supplemental characteristic combination of sample total red blood cell, after statistical procedures, expresses with figure or data mode.
Figure 25 is the same this colourity characteristic parameter statistical graph.Among the figure, the normalized colourity one-dimensional characteristic vector after use merging, the given threshold values of degree of filling in colors on a sketch is that H judges hypochromic erythrocyte, to be lower than the ratio of threshold values H be 40% to cell colourity in the sample.That is to say that hypochromic erythrocyte accounts for 40% of total red blood cell number in the sample in this sample.Figure 26 is that of Figure 25 changes expression-form.
Above-mentioned figure or data mode are expressed on the output unit and show, supply related personnel's reference.This output unit can be the display window on the red blood cell morphology analytical equipment of the present invention; It also can be the display that is connected with device; And is connected the display that is used for remote medical consultation with specialists with network, or express with the mode of printing, so that doctor's analysis.
This statistical graph can be expressed with the mode that many figure arrange, and is shown in figure 27.Also can convert the free hand drawing mode into shows.
In addition, the present invention relates to sample can be urine specimen, blood sample.What need particularly point out here is, blood sample is not made smear and handled, but analyzes after diluting with certain multiple, so just can not destroy the part cell in the sample because of smear.The present invention requires sample fresh, preferably obtains sample and checks that sample need not dye in 2 hours, but be not limited to not dye, and in check, need not use expensive reagent like this, thereby economy, and is pollution-free, helps environmental protection.